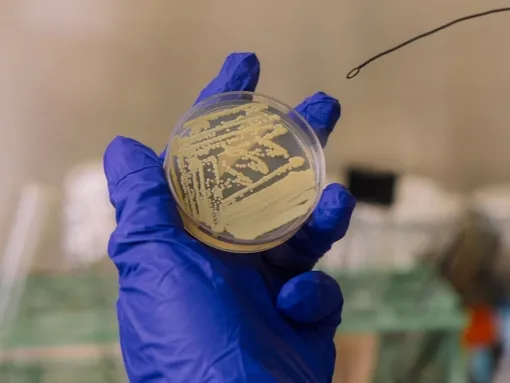

Несмотря на регулярную дезинфекцию, которую проводят в зонах сборки космических аппаратов, бактерия Tersicoccus phoenicis все же умудрилась выжить и там.
Обман века: бактерия прикидывается мертвой, чтобы пережить неблагоприятные условия

Микробиологи из Хьюстонского университета детально изучили этот феномен и выяснили, что же позволяет этой бактерии оставаться незамеченной. Оказалось, что микроорганизм впадает в анабиоз, при котором метаболизм снижается до рекордно низких значений, а сама бактерия перестает расти.
Tersicoccus phoenicis принадлежит к актинобактериям, которые в любой непонятной ситуации впадают в спячку, из-за чего становятся невидимыми для антибиотиков. В состоянии предельного покоя они ждут улучшения условий, а как только они наступают, пробуждаются, растут, размножаются и начинают свою разрушительную для организма деятельность.
Как разбудить спящую бактерию
Ученые решили прервать сладкий сон этой бактерии, использовав специальный белок. С его помощью уже выводили из спячки другой микроорганизм – Micrococcus luteus. А учитывая генетическое сходство с найденной бактерией, белок должен был подействовать и на нее.
И бактерию действительно удалось разбудить этим способом, что и подтвердило то, что она жива и потихоньку адаптируется к жизни в суровых условиях. А значит, есть опасность заражения космических кораблей и других планет.

Ясно и то, что бактерию интересует не только космическая отрасль: она вполне может обитать в больницах, операционных, фармацевтических лабораториях, на предприятиях, перерабатывающих пищевые продукты...
Исследователи отметили, что было бы полезно найти способ, который бы не позволил бактериям перейти в спящее состояние. И тогда антибиотики смогут их обнаружить и убить до того, как они перейдут в латентное состояние и навредят кому-то при выходе из него.